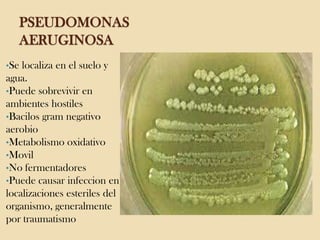
PSEUDOMONAS
AERUGINOSA
•Se

localiza en el suelo y
agua.
•Puede sobrevivir en
ambientes hostiles
•Bacilos gram negativo
aerobio
•Metabolismo oxidativo
•Movil
•No fermentadores
•Puede causar infeccion en
localizaciones esteriles del
organismo, generalmente
por traumatismo

El repaso del examen final de microbiología abarca diversos microorganismos patógenos, incluyendo cocos y bacilos grampositivos y gramnegativos, así como micoplasmas, chlamidias y virus. Se discuten características, infecciones y métodos de diagnóstico y tratamiento de estos patógenos, así como de las micosis y virus relevantes. Además, se incluyen detalles sobre la clasificación y el ciclo de vida de los virus y su impacto en la salud humana.